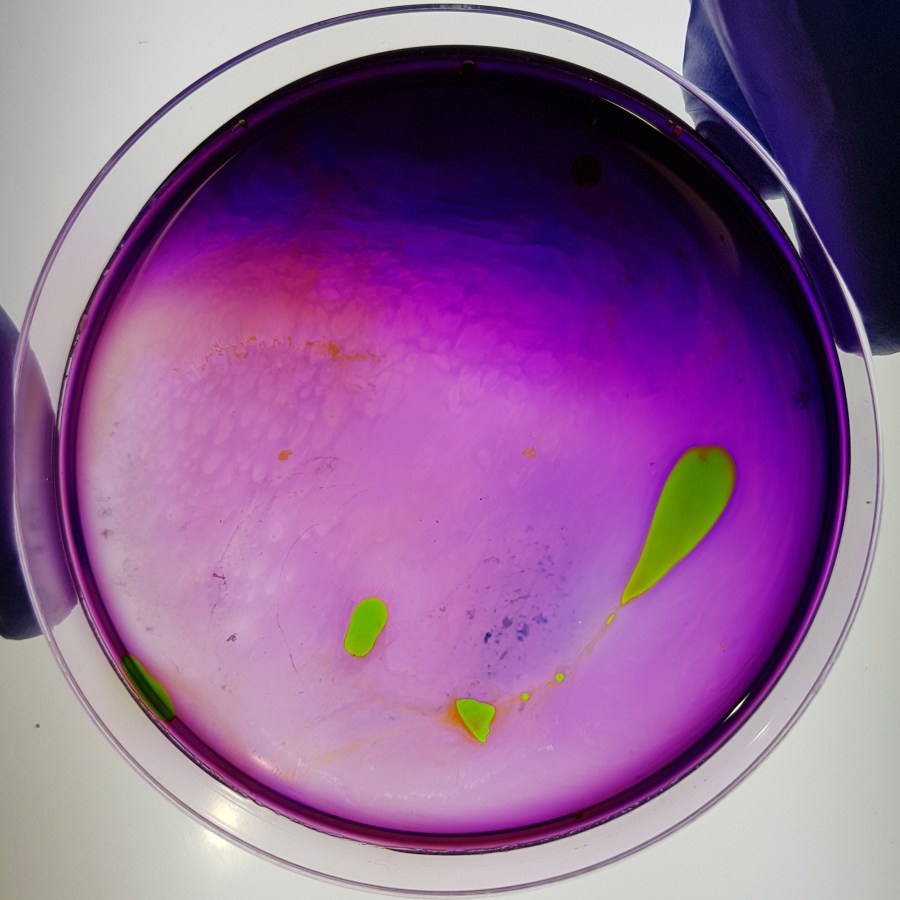

Wolfgang Ganter and Dr. Ana Domingos at IGC Lisbon – artist in residence
- Home
- About
- Think Tank – Leipzig 2016
- Teams
- Events
- Finding Affinities – At the Nexus of Art and Science – 28. April – 5. May 2019
- October 6-13, 2017 The Well-Tempered Brain at Faktor
- May 31, 2017 Well-Tempered Brain presents “What thinking sounds like”
- May 18, 2017 ArtSci Nexus Artistic Director Candace Goodrich to lecture at Svarta Havet -Konstfack
- May 11, 2017 John LaCava Phd – Art and Science Symposium in NYC
- GYA launches Science + Arts Work Group
- Nano-Thought Symphonies: The Well-Tempered Brain
- October 1, 2016 Gustav Hellberg to lecture at RAT Seoul
- The Directors
- Member Biographies
- Contact